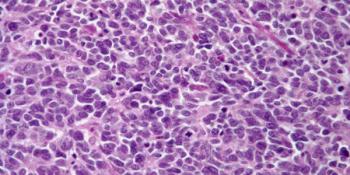

A 43-year-old woman presents with abdominal pain. Imaging detects a mass in the pancreas, and a biopsy is performed. What is your diagnosis?

Your AI-Trained Oncology Knowledge Connection!


A 43-year-old woman presents with abdominal pain. Imaging detects a mass in the pancreas, and a biopsy is performed. What is your diagnosis?

A 54-year-old woman presents with a skin lesion on her right arm, and a biopsy is performed. What is your diagnosis?

A 43-year-old man presents with a cough and chest pain. Imaging shows a mass in the lower lobe of his right lung, and a biopsy is performed. What is your diagnosis?

A 27-year-old woman presents with severe dyspnea. Imaging shows diffuse, bilateral infiltrates, and a biopsy is performed. What is your diagnosis?

A 27-year-old man presents with a skin lesion on the right side of his chest, and a biopsy is performed. What is your diagnosis?

A 46-year-old man presents with a cough and chest pain. Chest imaging shows a subpleural mass in his left upper lobe, and a biopsy is performed. What is your diagnosis?

A 53-year-old man presents with diarrhea of several weeks’ duration. A biopsy of the small intestine is obtained. What is your diagnosis?

A 62-year-old man presents with abdominal pain, and a stomach biopsy is obtained. What is your diagnosis?

A 43-year-old woman presents with abdominal pain. A mass is found in her right side, and a biopsy is performed. What is your diagnosis?

A 47-year-old man presents with a skin nodule on his upper back, and a biopsy is performed. What is your diagnosis?

A 30-year-old man presents with a lesion in his right adrenal gland, and a biopsy is performed. What is your diagnosis?

A 43-year-old woman is found to have a small tumor in her left fallopian tube, and a biopsy is performed. What is your diagnosis?

A 35-year-old HIV-positive man presents with enlarged lymph nodes, and a biopsy is performed. What is your diagnosis?

A 44-year-old man presents with cough and dyspnea. After further evaluation a bronchial mass is found, and a biopsy is performed. What is your diagnosis?

A 49-year-old woman presents with a lesion of the vulva, and a biopsy is performed. What is your diagnosis?
A 56-year-old man presents with a mass in the calf of his right leg, and a biopsy is performed. What is your diagnosis?

A 40-year-old woman presents with a mass in the right ovary, and a biopsy is performed. Based on the image shown, what is your diagnosis?

A 46-year-old man presents with abdominal pain. Imaging detects a mass at the level of the ileum, and a biopsy is performed. What is your diagnosis?

A 34-year-old woman presents with abdominal pain, and a duodenal biopsy is obtained. Based on the image shown, what is your diagnosis?

A biopsy is taken from the prostate of a 59-year-old man. Based on the image shown, what is your diagnosis?

A 41-year-old woman presents with an induration in her right breast, and a biopsy is performed. Based on the image, what is your diagnosis?

A biopsy is taken from the prostate of a 67-year-old man. Based on the image shown, what is your diagnosis?

A 42-year-old woman presents with an induration in her left breast, and a biopsy is performed. Based on the image shown, what is your diagnosis?

A 53-year-old woman presents with a mass in the right side of the parotid gland, and a biopsy is performed. Based on the image shown, what is your diagnosis?

A 38-year-old woman presents with an ill-defined nodule in her right breast, and a biopsy is performed. Based on the image shown, what is your diagnosis?

A 39-year-old man presents with a soft-tissue lesion in his wrist, and a biopsy is performed. Based on the image shown, what is your diagnosis?

A 42-year-old man presents with a lesion on his forehead, and a biopsy is performed. Based on the image shown, what is your diagnosis?

A 70-year-old man presents with a lesion in the right buccal mucosa of his lower lip. What is your diagnosis?

A 48-year-old man presents with swelling on the right side of his neck, and a biopsy is performed. What is your diagnosis?

A 52-year-old woman presents with a breast mass, and a biopsy is performed. What is your diagnosis?